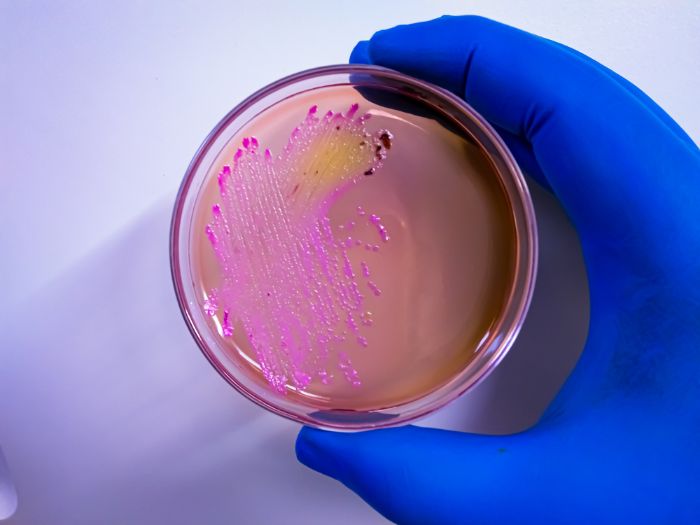
KS4 & KS5 biology: Can lactic acid fermentation disinfect manure?

Futurum Careers
Whether you’re a teacher of STEM, information technology, humanities, careers or social studies, we want to help you with all of these challenges and put the ‘wow’ into classrooms. We want to support you with resources that aim to engage all students regardless of their gender, ethnicity or background. There are multiple organisations and global initiatives that are focused on this mission, and our aim is to bring these resources together so that you can access them quickly and easily – For Free